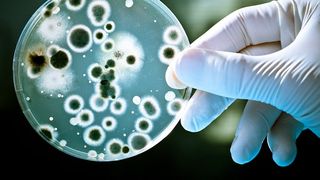
Bilanț Covid-19, 7 februarie. 81 de decese raporate în ultimele 24 de ore

Un nou studiu arată că există o corelație puternică între vitamina D și severitatea bolii COVID-19
Lipsa vitaminei D din organism reprezintă unul dintre cele mai mari pericole pentru pacienții care sunt infectați cu noul coronavirus, inclusiv cu varianta Omicron de SARS-Cov-2 care face ravagii în prezent în România.
Oamenii de știință din Israel spun că au strâns cele mai convingătoare dovezi de până în prezent, că nivelurile crescute de vitamina D pot ajuta pacienții cu COVID-19 să reducă riscul de îmbolnăvire gravă sau deces.
Citeste si: O româncă cu Covid-19 a murit în Italia. Aceasta a refuzat tratamentul
Suplimentele de vitamine, ajutor pentru imunitate
Cercetătorii de la Universitatea Bar Ilan și de la Centrul Medical Galilee spun că vitamina are un impact atât de puternic asupra severității bolii, încât pot prezice cum s-ar descurca oamenii dacă ar fi infectați pe baza vârstei și a nivelului de vitamina D, potrivit site-ului Times of Israel.
Lipsa vitaminei D crește semnificativ nivelurile de pericol, au concluzionat ei într-o nouă cercetare revizuită de colegi, publicată joi în jurnalul PLOS One.
Studiul se bazează pe cercetările efectuate în timpul primelor două valuri ale virusului din Israel, înainte ca vaccinurile să fie disponibile pe scară largă.
Medicii au subliniat că suplimentele de vitamine nu au fost un substitut pentru vaccinuri, ci mai degrabă o modalitate de a împiedica scăderea nivelului de imunitate, potrivit Alba24.
Vitamina D, critică în răspunsul la coronavirus
În iunie, cercetătorii au publicat descoperiri preliminare care arată că 26% dintre pacienții cu coronavirus care au murit aveau deficit de vitamina D imediat înainte de spitalizare, comparativ cu 3% care aveau niveluri normale de vitamina D.
Ei au stabilit, de asemenea, că pacienții spitalizați care aveau deficiență de vitamina D erau de 14 ori mai probabil, în medie, să ajungă în stare severă sau critică decât alții.
„Corelația dintre vitamina D și severitatea bolii este extrem de puternică”, a spus unul dintre medicii implicați în studiu.
„Oamenii ar trebui să învețe din asta că studiile care indică importanța consumului de vitamina D sunt foarte fiabile și nu se bazează pe date denaturate”, a spus el, potrivit sursei citate.
Ce alimente sunt bogate în vitamina D
Vitamina D ajută la reglarea cantității de calciu și fosfat din organism. Acești nutrienți sunt necesari pentru a menține sănătatea oaselor, dinților și mușchilor. Lipsa vitaminei D poate duce la deformări osoase, cum ar fi rahitismul la copii și dureri osoase cauzate de o afecțiune numită osteomalacie la adulți.
Vitamina D3 se regaseste doar in alimente de origine animala si poate fi produsa in timpul expunerii la soare, in timp ce vitamina D2 provine din plante si alimente fortificate.
Surse de vitamina D3
- Alimente cu conținut ridicat de vitamina D3
- Peștele gras: somon, macrou, cod, hering, sardine
- Lactatele
- Tofu
- Carnea de porc
- Carnea de vită (în special ficatul de vită)
- Ciupercile
- Gălbenușul de ou
- Cerealele fortificate cu vitamina D3
- Uleiul de ficat de cod
Punctam că vitamina D3 este o vitamină liposolubilă și pentru ca absorbția ei să se facă eficient avem nevoie de o alimentație bogată în grăsimi vegetale (avocado, nuci, migdale,